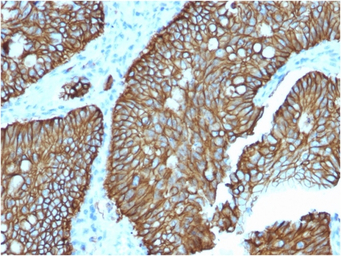
产品细节图片1

相关产品推荐更多 >
万千商家帮你免费找货
0 人在求购买到急需产品
- 详细信息
- 文献和实验
- 技术资料
- 免疫原:
Recombinant fragment (around aa 242-418) of human LI-Cadherin protein (CDH17).
- 亚型:
IgG2b
- 形态:
Liquid
- 保存条件:
Store as concentrated solution. Centrifuge briefly prior to opening vial. For short-term storage (1-2 weeks), store at 4ºC. For long-term storage, aliquot and store at -20ºC or below. Avoid multiple freeze-thaw cycles.
- 克隆性:
Monoclonal
- 标记物:
Unconjugated
- 适应物种:
Human
- 保质期:
12 months from the shipping date of the product.
- 抗原来源:
Human
- 目录编号:
GTX03259
- 级别:
Primary Antibodies
- 库存:
Available
- 供应商:
GeneTex
- 宿主:
Mouse
- 应用范围:
IHC-P, FACS, Protein Array
- 浓度:
0.2 mg/ml (Please refer to the vial label for the specific concentration.)
- 靶点:
LI-Cadherin
- 抗体英文名:
LI-Cadherin antibody [CDH17/2618]
- 抗体名:
LI-Cadherin 抗体 [CDH17/2618]
- 规格:
100 μg
IHC-P analysis of human colon tissue using GTX03259 LI-Cadherin antibody [CDH17/2618].

FACS analysis of MCF-7 cells using GTX03259 LI-Cadherin antibody [CDH17/2618].
Blue : Primary antibody
Red : Isotype control

The Z-score represents the strength of a signal that a monoclonal antibody (MAb) (in combination with a fluorescently-tagged anti-IgG secondary antibody) produces when binding to a particular protein on the HuProtTM array. Z-scores are described in units of standard deviations (SD's) above the mean value of all signals generated on that array. If targets on HuProtTM are arranged in descending order of the Z-score, the S-score is the difference (also in units of SD's) between the Z-score. S-score therefore represents the relative target specificity of a MAb to its intended target. A MAb is considered to specific to its intended target, if the MAb has an S-score of at least 2.5. For example, if a MAb binds to protein X with a Z-score of 43 and to protein Y with a Z-score of 14, then the S-score for the binding of that MAb to protein X is equal to 29.
风险提示:丁香通仅作为第三方平台,为商家信息发布提供平台空间。用户咨询产品时请注意保护个人信息及财产安全,合理判断,谨慎选购商品,商家和用户对交易行为负责。对于医疗器械类产品,请先查证核实企业经营资质和医疗器械产品注册证情况。
 文献和实验
文献和实验人钙粘蛋白E(Cadherin E)ELISA试剂盒 说明书
上海西唐生物科技有限公司 021-55229872, 65333639 www.westang.com 人钙粘蛋白E ( Cadherin E )ELISA 试剂盒 ( 用于血清、血浆、细胞培养上清液和尿液、唾液生物体液内 ) 原理 本实验采用双抗体夹心 ABC-ELISA 法。用抗人 Cadherin E 单抗包被于酶标板上,标准品和样品中的 Cadherin E与单抗结合
secondary antibody review -- data from 99 publications
cytometry used as a control to detect cell responses targeted antigen 7 Alexa Fluor 488 7 Cy3 8 goat IgG Alexa Fluor 488 1:2000 detect antibody binding in human embryonic kidney 293T cells Invitrogen 9 donkey
祝贺〖雅裕睿安〗成为Signalway Antibody(SAB)独家
antibody unconjugated; 货号21337,产品描述:GAPDH Antibody;规格 50 ul / 100 ul; 货号3052,产品描述:Rabbit anti-Human IgG secondary antibody HRP conjugated; 货号300904050,产品描述:One-Hour Western kit,10 ml / bottle x 3;
 技术资料
技术资料暂无技术资料 索取技术资料





![GADD45G antibody [C1C3]](https://img1.dxycdn.com/2023/0711/255/2344116916935858761-14.jpg!wh200)


